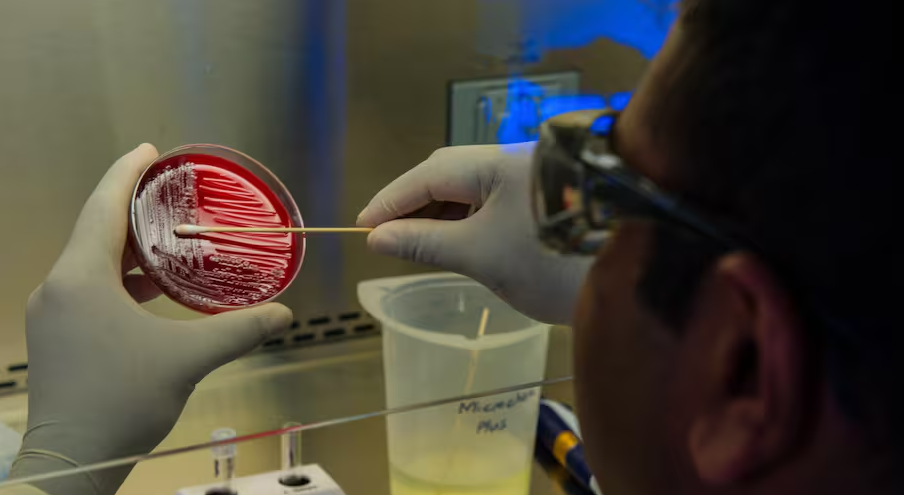

MUNDO
24 de noviembre de 2025
Alerta de la OMS por el virus de Marburgo: qué es y cómo se contagia
La Organización Mundial de la Salud confirmó un brote en Etiopía y elevó el nivel de riesgo, mientras los sistemas de salud locales trabajan para evitar nuevas cadenas de transmisión.
La Organización Mundial de la Salud (OMS) confirmó un nuevo brote del virus Marburgo en Etiopía y emitió una alerta internacional que encendió las alarmas en la comunidad científica global.
El organismo señaló que ya fueron detectados seis casos confirmados, incluidos tres fallecidos, además de otros tres probables que también resultaron mortales, todos localizados en la ciudad de Jinka, al sur del país.

La identificación del patógeno fue realizada por el laboratorio nacional de referencia, y actualmente se mantiene bajo vigilancia sanitaria a más de 200 personas que estuvieron en contacto con los casos sospechosos. A pesar de que las cifras pueden modificarse, el brote representa el primero documentado en territorio etíope, un factor que obliga a reforzar las medidas de control.
Las autoridades aún no localizaron el origen exacto de la transmisión. Sin embargo, se constató la presencia de murciélagos frugívoros en las zonas afectadas, reconocidos como reservorio natural del virus. Este hallazgo orienta parte de la investigación epidemiológica inicial.
La OMS calificó como elevado el riesgo para la salud pública dentro de Etiopía, especialmente debido a la presión que enfrentan los servicios sanitarios por la coexistencia de otros brotes activos de cólera, sarampión y dengue. Esta situación genera un escenario complejo para la rápida contención del virus.
Tras la confirmación oficial, el Ministerio de Salud etíope declaró una emergencia sanitaria luego de analizar un grupo de casos sospechosos cerca de la frontera con Sudán del Sur. Durante los últimos días, equipos de la OMS y del Centro Africano para el Control y la Prevención de Enfermedades (Africa CDC) fueron desplegados en la zona con el fin de fortalecer la vigilancia epidemiológica, implementar protocolos de aislamiento y reforzar la búsqueda activa de contactos.
En este marco, la ministra Mekdes Daba sostuvo que se incrementaron “las acciones de vigilancia y prevención” en toda la región. La respuesta de los organismos internacionales apunta a contener una enfermedad que puede presentar tasas de letalidad de hasta el 88%, aunque estas cifras se reducen cuando existe atención médica temprana y adecuada.

El Ministerio de Salud de Sudán del Sur, al considerar el riesgo de expansión hacia su territorio, emitió una advertencia pública dirigida a varios condados fronterizos. Las autoridades remarcaron la importancia del “lavado frecuente de manos y la evitación del contacto con fluidos corporales” como medidas esenciales para reducir la transmisión.
La situación también llevó al director del Africa CDC, Jean Kaseya, a describir el panorama como particularmente delicado en función de “la fragilidad del sistema de salud en Sudán del Sur”. Para el organismo, la combinación de vulnerabilidad sanitaria y movilidad transfronteriza agrava las posibilidades de una expansión regional. “La situación es especialmente preocupante”, afirmó.
Un virus altamente letal
El virus de Marburgo, perteneciente a la misma familia que el ébola, está catalogado entre los patógenos más peligrosos del continente africano. Proviene de murciélagos frugívoros y su transmisión hacia humanos ocurre mediante contacto directo con fluidos corporales o con superficies contaminadas, como ropa de cama o utensilios médicos.
Los síntomas suelen aparecer de forma brusca con fiebre, dolores musculares intensos, vómitos, diarrea profusa y, en los casos más graves, hemorragias internas y externas. La OMS recuerda que “No existe actualmente una vacuna ni un tratamiento autorizado para combatir el virus, lo que incrementa el riesgo en caso de brotes”. La atención se centra, por ello, en medidas de soporte clínico y control epidemiológico.

Desafíos regionales y antecedentes
Este nuevo brote en Etiopía se suma a una larga lista de episodios registrados en África, incluyendo casos en Ruanda, Tanzania, Angola, Congo, Uganda, Kenia, Sudáfrica, Ghana y Guinea Ecuatorial. La repetición de eventos a lo largo del tiempo muestra las dificultades estructurales para erradicar el riesgo en regiones donde los sistemas sanitarios enfrentan limitaciones importantes.
La OMS señala que la vigilancia permanente y la cooperación internacional son esenciales para evitar una propagación a gran escala. La ausencia de tratamientos específicos y la rápida progresión clínica de la enfermedad refuerzan la necesidad de respuestas coordinadas.
Canal 26
-
#Escuchá La 97.1 todo el día, hacé click acá📻
#Descarga la App de #RTuc haciendo click acá📲​
-





